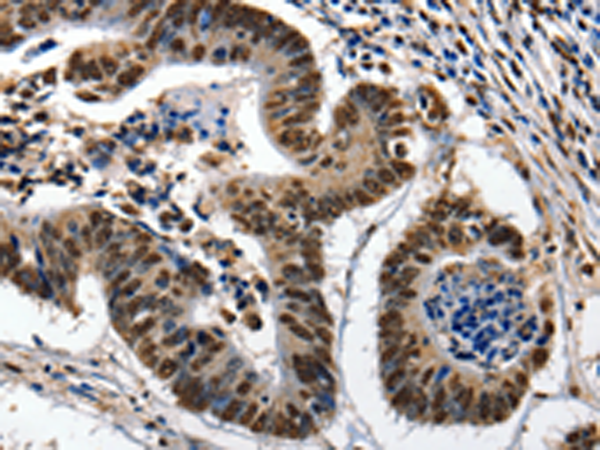
一抗

儲 存: 冷凍(-20℃)
技術(shù)規(guī)格
|
Background: |
This gene encodes a member of the kallikrein subfamily of serine proteases. These enzymes have diverse physiological functions and many kallikrein genes are biomarkers for cancer. The encoded protein has chymotrypsin-like activity and plays a role in the proteolysis of intercellular cohesive structures that precedes desquamation, the shedding of the outermost layer of the epidermis. The encoded protein may play a role in cancer invasion and metastasis, and increased expression of this gene is associated with unfavorable prognosis and progression of several types of cancer. Polymorphisms in this gene may play a role in the development of atopic dermatitis. Alternatively spliced transcript variants encoding multiple isoforms have been observed for this gene, which is one of fifteen kallikrein subfamily members located in a gene cluster on chromosome 19. |
|
Applications: |
ELISA, IHC |
|
Name of antibody: |
KLK7 |
|
Immunogen: |
Fusion protein of human KLK7 |
|
Full name: |
kallikrein-related peptidase 7 |
|
Synonyms: |
hK7, SCCE, PRSS6 |
|
SwissProt: |
P49862 |
|
ELISA Recommended dilution: |
1000-5000 |
|
IHC positive control: |
Human colon cancer and human ovarian cancer |
|
IHC Recommend dilution: |
25-100 |

 購物車
購物車 幫助
幫助
 021-54845833/15800441009
021-54845833/15800441009